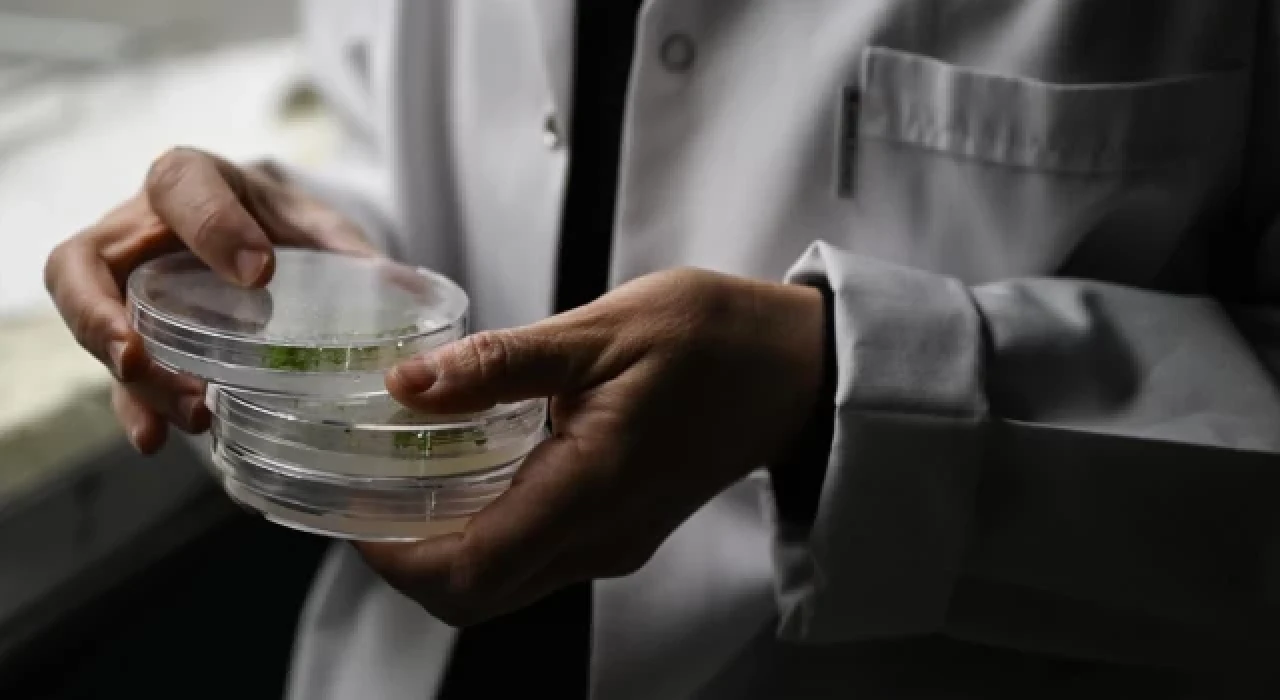

İlk Türk astronotu Alper Gezeravcı, Uluslararası Uzay İstasyonu'nda (ISS) gerçekleştirdiği çalışmalarına 6. deneyiyle devam etti.
Gezeravcı, bugün, Nişantaşı Üniversitesinden Oğuzhan Aydemir'in proje yöneticisi olduğu, "OKSİJEN SATURASYONU" deneyini hayata geçirdi.
Söz konusu deneyle, yapay zeka desteğiyle verilen havanın oksijen seviyesi hesaplanarak düşük yer çekiminin sebep olduğu farklılıklar ve rahatsızlıkların tanımlanması hedefleniyor.
Şimdiye kadar 5 deney çalışmasını başlattı
Gezeravcı, ISS'ye ulaştığı günden bu yana 5 deneyi hayata geçirdi.
Astronot Gezeravcı, Tuz Gölü'nde yetişen endemik Schrenkiella Parvula isimli halofit bitkinin uzay ortamına karşı verdiği fizyolojik ve moleküler tepkileri araştıran "EXTREMOPHYTE", gelecekte uzayda yaşayacak yüksek sayıda insanın ihtiyaç duyacağı besinlerin sağlanması ve kapalı yaşam ortamlarındaki çevresel kontrollere destek vermesi için yeni bitkiler geliştirmeye yönelik ilk adım olan "CRISPR-GEM" ve mikroalg türlerinin uzayda yaşam destek sistemlerinde kullanılmalarının mümkün olup olmadığının araştırıldığı "UzMAn" deneylerine devam ediyor.
Gezeravcı, uzay ortamında alglerin, karbondioksitten oksijen rejenerasyonu, ek gıda temini, su iyileştirme, yaşam destek alanlarında kullanılmasını araştıran "ALGALSPACE" ve uzayda yaşamaya karşı oluşan hayati tepkimelerin "vokal kord" kaynaklı değişimlerle tespiti ve düşük yer çekimsizliğin sebep olduğu rahatsızlıkların ses frekanslarıyla tanımlanmasını sağlayacak "VOKALKORD" deneylerini de sürdürüyor.